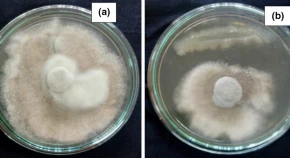
Isolation and Identification of antifungal metabolite producing endophytic Bacillus subtilis (S17) and its in vitro effect on Colletotrichum falcatum causing red rot in sugarcane

Vol 33 Issue 3, September 2020
Total Articles: 25

Structural characterization of phenolic content, antioxidant and antibacterial activities of Coffea arabica green seeds
Research Articles
Views: 4355
Pages: 466-474
Published: 21 June, 2020
Doi: 10.1007/s42535-020-00130-9

Identification of useful recombinants from interspecific hybrids of Citrullus lanatus and C. colocynthis
Research Articles
Views: 4843
Pages: 475-482
Published: 27 June, 2020
Doi: 10.1007/s42535-020-00131-8

Transition in quality attributes of true potato seed (TPS) under split application of nitrogen and boron
Research Articles
Views: 4034
Pages: 483-492
Published: 19 June, 2020
Doi: 10.1007/s42535-020-00127-4
Isolation and Identification of antifungal metabolite producing endophytic Bacillus subtilis (S17) and its in vitro effect on Colletotrichum falcatum causing red rot in sugarcane
Research Articles
Views: 4469
Pages: 493-503
Published: 06 July, 2020
Doi: 10.1007/s42535-020-00133-6

Foliar micro-morphology: a promising tool to improve survival percentage of tissue culture raised plantlets with special reference to in vitro propagation of Vitex negundo L.
Research Articles
Views: 4460
Pages: 504-515
Published: 29 June, 2020
Doi: 10.1007/s42535-020-00134-5

Tree species diversity and biomass carbon assessment in undisturbed and disturbed tropical forests of Dibru-Saikhowa biosphere reserve in Assam North-East India
Research Articles
Views: 4756
Pages: 516-537
Published: 30 June, 2020
Doi: 10.1007/s42535-020-00135-4

Morphometric characterization of Apis species (Hymenoptera: Apoidea)
Research Articles
Views: 4068
Pages: 538-544
Published: 02 July, 2020
Doi: 10.1007/s42535-020-00136-3

Ultraviolet-B radiation induces physiological, biochemical, and structural changes in Viola odorata
Research Articles
Views: 3923
Pages: 545-554
Published: 16 July, 2020
Doi: 10.1007/s42535-020-00139-0

Characterization and biocontrol measures of Pseudomonas syringae pv. syringae associated with citrus blast disease
Research Articles
Views: 4199
Pages: 555-569
Published: 22 July, 2020
Doi: 10.1007/s42535-020-00138-1